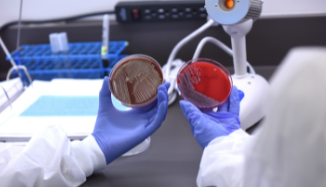
Carolinas College and Winthrop University partner on joint biology degree

Carolinas College News
-

Carolinas College Achieve 100% NCLEX Pass Rate
Carolinas College of Health Sciences is proud to share that Associate Degree in Nursing (ADN) graduates continue to demonstrate exceptional academic and professional readiness.
-

Carolinas College Receives Torch Award for Student Success and Completion
Carolinas College of Health Sciences has been recognized with the Torch Award for Student Success and Completion by the Southern Association of Colleges and Schools Commission on Colleges (SACSCOC).
-

The Case for Integrative Health Education at Carolinas College of Health Sciences
Educating a new generation of healthcare professionals to empower communities and individuals to optimize their health and well-being through evidence-based, sustainable practices is a progressive step forward.
-

Meg Patchett, PhD, Named Interim President
Carolinas College Names Meg Patchett, PhD, as Interim President.
-

2023 Annual Giving Campaign
We invite you to make an investment in our students and the future of healthcare.
-

Carolinas College Travel Group
Join us for an upcoming adventure! Amsterdam, Luxembourg and Brussels (with extension to Bruges).
-

New Leadership Bachelor’s Degree Offered
Carolinas College announces the new Bachelor of Science in Health Sciences Leadership concentration.
-

Faculty Accomplishments
Sixteen outstanding faculty making Carolinas College a better place to work and learn.
-
Carolinas College Partners with Winthrop on Joint Biology Degree
Winthrop students will spend their final year obtaining their medical laboratory science certification.
-

Mom Follows Son's Path Into Nursing
After putting her dream on hold, Melissa Milligan decided it was time to finally pursue the career path she'd always wanted.
-

Nursing Grads Step Up to Fill Healthcare Need
Two of our recent graduates discuss what it's like to enter the frontlines of healthcare during a pandemic.
-

New Instructor Brings Lab Experience to the Classroom
Saravanan Neelakantan has a range of experience, from research to performing COVID-19 tests.
-
-

Vaccine Clinic Makes Impression on Students
Nursing students gain experience, memories working COVID vaccine clinic
-

College Welcomes New Board Member
Board leadership also welcomes new chair, vice chair
-
-

Busy Mom Working to Advance Nursing Career
Learn why this next step is important for her family and her career.
-

Alumnae Play Role in Lab During Pandemic
Read about two college alumnae who are making a difference during the fight against COVID-19.
-

Nursing Grad Works the Frontlines of a Pandemic
Stephanie Cooper talks about what it's like to be a healthcare worker during COVID-19.
-

Carolinas College is Relocating
For the past 25 years, the Rankin Education Center has been home to Carolinas College.
-

Pulse Weekend Gives Students New Perspective
Students see big benefits from pairing with others during this immersive experience.
-

Nursing Program Changes to Benefit Students, Get Nurses Into Field Sooner
The new changes reflect how Carolinas College is responding to the current demand.
-

GenHERation Program Visits Carolinas College
It's part of a nationwide effort to inspire young women.




